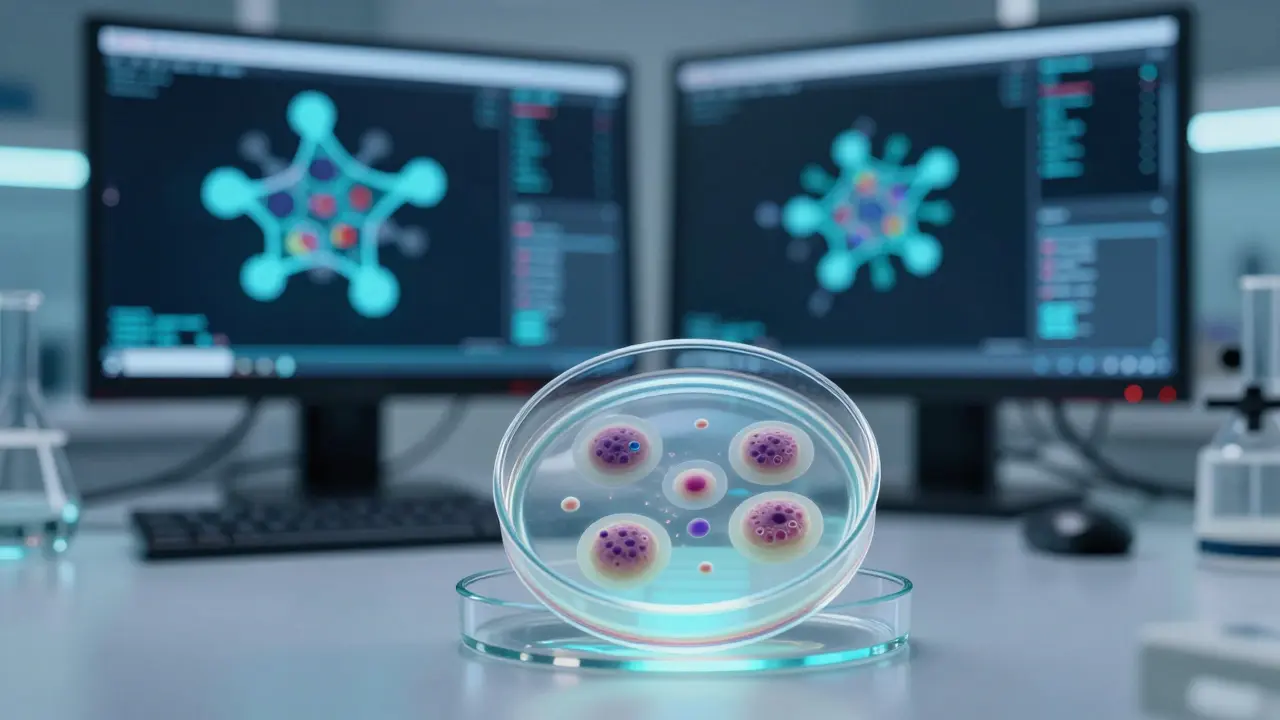
Moderní laboratorní testování na lidských buňkách místo zvířat.

Koupíte si v drogerii šampon, který vypadá skvěle a voní ještě lépe, ale v hlavě vám někde zní otázka: "Kde se vlastně vzala ta jistota, že je bezpečný?" Bohužel pro mnohé z nás odpověď často zahrnuje laboratorní krysy, králíky nebo morčata. Pravda je taková, že i v roce 2026 je hranice mezi "etickou“ a „tradiční“ kosmetikou někdy velmi tenká. Mnoho firem používá marketingové triky, aby vypadaly přívětivě k přírodě, zatímco za zavřenými dveřmi stále probíhá to, co chceme zastavit. Pokud hledáte cruelty-free kosmetika, nestačí jen věřit nápisům na obalech. Musíte vědět, co hledat a komu věřit.
Rychlý přehled: Co musíte vědět
- Hledejte certifikáty jako Leaping Bunny nebo PETA, ne jen nápisy „bez testování“.
- Cruelty-free neznamená automaticky vegan (produkt nemusí obsahovat živočišné složky, ale může být testován, nebo naopak).
- Pozor na značky, které jsou cruelty-free, ale patří pod obří koncerny, které stále testují.
- Čínský trh byl dlouho hlavním problémem, dnes se ale pravidla pomalu mění.
Rozpleťme si pojmy: Cruelty-free vs. Vegan
Když stojíte před regálem, často vidíte oba tyto pojmy a myslíte si, že jsou to synonyma. Ve skutečnosti je to tak, že Cruelty-free is označení pro produkty, které nebyly testovány na zvířatech v žádné fázi výroby, ani jejich jednotlivé ingredience. To znamená, že výrobce nepoužíval zvířata k ověření toxicity nebo podráždění kůže.
Na druhé straně máme Veganská kosmetika is produkt, který neobsahuje žádné ingredience živočišního původu, jako je včelí vosk, lanolin z ovčí vlny nebo karmín z mravenců. Může se stát, že produkt je veganský (neobsahuje mléko), ale byl testován na zvířatech. A může být pravý opak - produkt je cruelty-free, ale obsahuje med.
Jak poznáte skutečně etickou značku?
Slovo „přirozený“ nebo obrázek králíčka, který firma nakreslila sama, nic neznamená. V marketingu se tomu říká greenwashing. Abychom měli jistotu, musíme hledat nezávislé certifikace. Nejuznávanější je Leaping Bunny is mezinárodní zlatý standard pro cruelty-free produkty, který vyžaduje přísné audity celého dodavatelského řetězce. Pokud uvidíte tento symbol, víte, že firma neprodává své produkty v zemích, kde je testování na zvířatech zákonným požadavkem.
Další častý znak je logo PETA is organizace za práva zvířat, která udržuje seznam značek, jimž výrobci přislibili, že netestují na zvířatech. PETA je skvělým startovním bodem, ale její systém je méně přísný než Leaping Bunny, protože se spoléhá více na tvrzení firmy než na fyzické kontroly v laboratořích.
| Certifikace | Co potvrzuje | Přísnost kontroly | Zahrnuje dodavatele? |
|---|---|---|---|
| Leaping Bunny | Žádné testování na zvířatech | Velmi vysoká (audity) | Ano |
| PETA (Cruelty-Free) | Žádné testování na zvířatech | Střední (deklarace) | Částečně |
| Choose Cruelty Free | Žádné testování na zvířatech | Vysoká | Ano |
Značky, kterým můžete věřit (a kde si dát pozor)
Pokud hledáte konkrétní jména, existuje několik kategorií. Prvním jsou „čisté“ značky, které byly založeny jako cruelty-free od prvního dne. Mezi ně patří například The Ordinary is značka zaměřená na transparentní složení a dostupnou cenu, která striktně odmítá testování na zvířatech nebo Lush is ručně vyráb které cosmetics, známé svými veganskými mýdly a bath bombs. Tyto firmy mají etiku v DNA a nemusíte u nich přemýšlet nad každým produktem.
Pak jsou tu značky, které jsou cruelty-free, ale patří pod giganty jako L'Oréal is jeden z největších kosmických koncernů na světě, který v některých regionech stále využívá tradiční testování nebo Estée Lauder is luxusní kosmetický dům, který má v portfolio značky s různými přístupy k testování. Tady začíná ta složitost. Může se stát, že konkrétní řada produktů je cruelty-free, ale vaše peníze stále putují do firmy, která v jiné části světa testuje na zvířatech. Je to vaše osobní rozhodnutí, zda takový kompromis přijmete.

Problém s globálními trhy a legislativou
Kde se nejčastěji taje? V exportu. Dlouho byla Čína is největší trh s kosmetikou, který do nedávna vyžadoval zákonné testování všech importovaných kosmetických produktů na zvířatech. To znamenalo, že pokud chtěla značka prodávat v čínských kamenných obchodech, musela své produkty nechat otestovat. Mnoho firem tedy v Evropě tvrdilo, že jsou cruelty-free, ale v Číně dělaly úplně něco jiného.
Dnes se situace v Číně pomalu zmírňuje a některé kategorie produktů už testování nevyžadují, ale stále je to šedá zóna. Pokud chcete mít absolutní jistotu, hledejte značky, které otevřeně deklarují, že neprodávají své produkty v žádné zemi, kde je testování povinné. To je ten nejvyšší standard etiky.
Jak vyčíst složení: Co jsou „skryté“ živočišné složky?
Když už víte, že značka netestuje, možná vás zajímá, zda je produkt i veganský. Složení na obalech je často psané chemickým jazykem, který není pro běžného člověka srozumitelný. Tady je pár věcí, na které si dát pozor:
- Karmín (Carmine): Červené barvivo z drcených mravenců. Často v rtencích.
- Lanolin: Tuk z vlny ovcí. Najdete ho v mnoha krémech na rty a ruky.
- Glycerin (živočišný): Může být rostlinný, ale i zvázaný se zpracováním zvířecích tuků.
- Squalene: Pokud není označen jako „plant-derived“, může pocházet z jepských cukrů.
- Kolagen: Většinou se získává z kostí a kůží hovádů nebo ryb.
Když uvidíte nápis „Vegan“, znamená to, že tyto složky v produktu nejsou. Pokud je produkt jen „Cruelty-free“, mohou tyto složky stále obsahovat, protože jejich přítomnost v krémičku neznamená, že byl produkt testován na králíku.
Praktický postup pro nákup etické kosmetiky
Abychom se nezbláznili z čtení každé etikety, doporučuji tento jednoduchý systém. Nejdříve si stáhněte aplikaci jako Cruelty-Free nebo Bunny Free. Stačí v nich vyhledat název značky a hned vidíte její status. Pokud aplikaci nemáte, postupujte takto:
- Hledejte logo Leaping Bunny. Je to nejrychlejší cesta k pravdě.
- Zkontrolujte web výrobce. Pokud tam najdete pouze obecné fráze jako „milujeme zvířata“ bez konkrétních certifikací, buďte skeptičtí.
- Pokud značka patří pod obří koncern, rozhodněte se, zda vám vadí podporovat mateřskou firmu.
- Pokud hledáte veganský produkt, hledejte symbol V-Label nebo nápis „100% Vegan“.
Budoucnost: Alternativní metody testování
Dobrou zprávou je, že dnes už nemusíme volit mezi bezpečností a etikou. Věda se posunula dopředu. In vitro testování is metoda testování v laboratorních kल्टीvovaných lidských buňkách, která je často přesnější než testy na zvířatech. Existují i počítačové modely, které dokážou předpovědět reakci kůže na látku s extrémní přesností.
Problémem není nedostatek technologií, ale setrvačnost zákonů a lobby velkých firem. Přesto vidíme trend, kdy i staré značky začínají své portfolio čistit a přecházet na etické metody. Čím více budeme jako zákazníci vyžadovat transparentnost, tím rychleji zvířata z laboratoří zmizí.
Je rozdíl mezi „bez testování na zvířatech“ a „cruelty-free“?
V běžné mluvě se používají stejně, ale marketingově může být „bez testování“ zavádějící. Firma může tvrdit, že ona sama netestuje, ale využívá dodavatele, kteří testy provádějí, nebo prodává produkty v zemích, kde je testování povinné. Termín „cruelty-free“ v kombinaci s certifikací (např. Leaping Bunny) je mnohem spolehlivější, protože zaručuje absenci testování v celém řetězci.
Které certifikáty jsou nejspolehlivější?
Za nejspolehlivější je považován Leaping Bunny, protože vyžaduje nezávislé audity a kontrolu dodavatelů. PETA je také velmi populární a pomáhá identifikovat velké množství značek, ale její proces certifikace je založen více na deklaracích firmy než na přísných kontrolách.
Je veganská kosmetika vždy cruelty-free?
Není. Veganismus se týká složení (absence živočišných ingrediencí), zatímco cruelty-free se týká procesu testování. Může existovat produkt, který neobsahuje žádné živočišné složky, ale byl přesto testován na zvířatech, aby splnil zákonné požadavky určitého trhu.
Co dělat, když si nejsem jistý u své oblíbené značky?
Nejlepší je navštívit oficiální databázi PETA nebo Leaping Bunny. Pokud tam značka není, můžete zkusit poslat firmě e-mail s konkrétním dotazem: „Do testujete své produkty nebo ingredience na zvířatech a prodáváte své zboží v zemích, kde je testování povinné?“. Upřímné firmy vám odpoví transparentně.
Jsou alternativní metody testování stejně bezpečné?
Ano, a často jsou i bezpečnější. Testování na lidských buňkách (in vitro) nebo pomocí počítačových simulací lépe odráží reakci lidského organismu než testování na králíku nebo myši, protože genetika zvířat se od lidské liší. Moderní věda umožňuje ověřit bezpečnost látky bez zbytečného utrpení zvířat.
Další kroky pro etický životní styl
Pokud vás zaujala cesta k cruelty-free kosmetice, můžete své úsilí rozšířit i do dalších oblastí. Zkuste zkontrolovat své čistící prostředky na domácnost - i zde existují značky, které se vyhýbají testování na zvířatech. Můžete také podpořit organizace, které bojují za změnu legislativy v oblasti zvířecích experimentů.
Nezapomeňte, že i malý krok pomáhá. Nemusíte vyhodit celou svou koupelnu hned dnes. Stačí, že při každém nákupu nové řasy krému nebo šamponu zvolíte tu variantu, která zvířatům neublížila. Vaše peněženka je v tomto případě nejmocnější hlas pro změnu světa k lepšímu.


